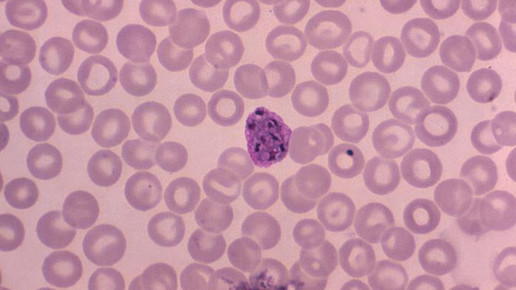
plasmodium malaria cdc dr-mae-melvin

Covid-19: WHO kündigt globale Studie an
Aktuell stehen vier Wirkstoffkombinationen im Zentrum der Corona-Forschung. Wissenschaftler testen hierfür auch bereits zugelassene Arzneimittel, so könnte ein potentiell wirksamer Kandidat schneller in der Praxis angewandt werden. Vielversprechend scheinen das Malariamittel Chloroquin und der Abkömmling Hydroxychloroquin, das HIV-Medikament Kaletra (Lopinavir/Ritonavir), Kaletra in Kombination mit Beta-Interferonen und das Virusstatikum Remdesivir, welches bereits gegen Ebola eingesetzt wurde. Die WHO kündigte nun eine großangelegte, weltweite Studie an – sie trägt den Namen Solidarity.
Am Freitag kündigte die Weltgesundheitsorganisation (WHO) die globale Studie an, um herauszufinden, welche Arzneistoffe gegen die Infektion mit dem neuen Coronavirus wirken. Es ist eine beispiellose Studie, die schnell zu umfassenden Ergebnissen führen soll. Ziel ist es, möglichst viele Daten während der Pandemie zu sammeln. Das Studiendesign wurde bewusst einfach gehalten, sodass auch Krankenhäuser in der jetzigen Situation teilnehmen können. An der Solidarity Studie nehmen somit tausende Patienten aus zahlreichen Ländern teil.
Lopinavir/Ritonavir (Kaletra, AbbVie)
Lopinavir hemmt die HIV-Protease, hierbei handelt es sich um ein Enzym, das beim Aufbau neuer Viren essentiell ist. Das Schlüsselenzym ist dafür zuständig, das von der befallenen Wirtszelle produzierte Protein zu spalten. Durch die Hemmung des Enzyms kommt es zur Anhäufung nichtinfektiöser Virus-Vorstufen. Lopinavir wird zusammen mit Ritonavir verabreicht, um den Abbau von Lopinavir zu verlangsamen. Durch die fixe Kombination der beiden Proteasehemmer verbleibt mehr Wirkstoff länger im Körper.
Der Wirkstoff erwies sich zum Teil als wirksam bei mit dem MERS-Virus infizierten Krallenaffen. Kaletra wurde auch bei SARS- und MERS-Patienten getestet – die Ergebnisse dieser Studien sind nicht eindeutig. Nach dem Sars-CoV-2 Ausbruch in Wuhan hat AbbVie Kaletra-Dosen im Wert von zwei Millionen Dollar für den experimentellen Einsatz nach China verschickt.
Der erste Anwendungsversuch war nicht sehr erfolgsversprechend. Ärzte in Wuhan gaben 199 Patienten zweimal täglich zwei Tabletten der fixen Kombination Lopinavir / Ritonavir plus Pflege oder keine Medikation, sondern Pflege allein. Im Ergebnis gab es keinen signifikanten Unterschied zwischen den Gruppen, berichteten sie am 15. März im The New England Journal of Medicine (NEJM). Die Autoren berichteten aber ebenfalls, dass die Patienten sehr krank waren, über 20 Prozent starben, es besteht der Verdacht, dass die Behandlung möglicherweise zu spät begonnen wurde.
Lopinavir/Ritonavir (Kaletra, AbbVie) in Kombination mit Beta-Interferonen
Solidarity wird auch einen Studienarm haben, der die fixe Kombination der Proteaseinhibitoren mit Beta-Interferon kombiniert. Diese Glykoproteine sind Botenstoffe, die natürlich im Körper vorkommen. Sie gehören zur Familie der Zytokine und wirken antiviral, antiproliferativ, antitumoral und immunmodulierend. Das Molekül ist an der Regulierung von Entzündungen beteiligt. Auch dieser Wirkstoff hat bei mit MERS infizierten Krallenaffen eine Wirkung gezeigt. Eine Kombination der drei Medikamente wird derzeit in der ersten randomisierten kontrollierten Studie für diese Krankheit bei Mers-Patienten in Saudi-Arabien getestet.
Die Anwendung von Beta-Interferonen könnte, je nach Krankheitsstadium, auch Gefahren bergen. Wird es zu spät im Krankheitsverlauf verabreicht, kann es zu schlimmen Gewebeschäden kommen. Beta-Interferon ist als Orphan-Drug auch zur Behandlung eines akuten Lungenversagens indiziert.
Beta-Interferon gehört zu den Typ-I-Interferonen und bindet an IFNAR-Rezeptoren. Hierbei handelt es sich um Interferon-alpha/beta-Rezeptoren, die als Transmembranrezeptor überall im Körper vorkommen. Eine Wirkung besteht in der Verstärkung der Suppressoraktivität peripherer Lymphozyten.
Aktuell wird rekombinantes Beta-Interferon als Mittel der Wahl zur Basistherapie der schubförmigen Multiplen Sklerose (MS) eingesetzt. Der Arzneistoff verlangsamt das Fortschreiten der Erkrankung und kann zudem die Frequenz der Schübe minimieren. Studienergebnisse legen nahe, das der therapeutische Einsatz möglichst früh im Krankheitsverlauf erfolgen sollte.
Remdesivir
Ursprünglich wurde das Virusstatikum von Gilead zur Behandlung von Ebola entwickelt. Der Wirkstoff aus der Gruppe der Nukleosid-Analoga und RNA-Polymerase-Inhibitoren kann bei Infektionen mit RNA-Viren eingesetzt werden. Somit besteht ein breites Wirkspektrum, unter anderem gegen verschiedene Coronaviren, Ebolaviren und RSV (Respiratory-Syncytial-Virus). Die Wirkung beruht auf der Hemmung der RNA-Polimerase. Während des Ebolaausbruchs im vergangenen Jahr testeten Wissenschaftler den Wirkstoff in der Demokratischen Republik Kongo zusammen mit drei anderen Behandlungen. Gegen Ebola zeigte sich keine ausreichende Wirkung. In vitro konnten Forscher der Universität von North Carolina in Chapel Hill zeigen, dass Remdesivir Coronaviren, die zum Ausbruch von Sars und Mers führen, hemmen kann.
Das New England Journal of Medicine (NEJM) schrieb über einen Fallbericht, bei dem ein in den USA diagnostizierter COVID-19-Patient nach der Gabe von Remdesivir einen besseren Allgemeinzustand erreichte. Es gibt weitere solcher Einzelberichte, so konnte der Zustand eines kalifornischen Patienten, der in Lebensgefahr schwebte, durch die Gabe von Remdesivir ebenfalls stabilisiert werden.
Nun gilt ein erster Mensch in Europa als geheilt durch die Gabe des Virusstatikums: Die italienische Nachrichtenagentur ANSA berichtete, dass ein 79-jähriger Mann aus Italien, der an Covid-19 erkrankt war, geheilt aus der Klinik entlassen werden konnte. „Wir haben den ersten echten Geheilten, der mit dem experimentellen Medikament Remdesivir behandelt wurde“, erzählt Professor Matteo Bassetti, Leiter der Klinik für Infektionskrankheiten am Policlinico San Martino in Genua. Der Patient hat bereits zwei negative Abstriche. „Er wird bald in sein Zuhause in der Lombardei zurückkehren können und das stimmt uns sehr hoffnungsvoll: Das Medikament scheint zu wirken. Wir haben noch andere Patienten in Behandlung.“
Chloroquin / Hydroxychloroquin
In einer ersten chinesischen klinischen Studie erwies sich Chloroquin als wirksam gegen Sars-CoV-2. Der Wirkmechanismus des ehemaligen Malariamittels gegen Coronaviren ist noch nicht vollständig geklärt. Vereinfacht lässt sich sagen, dass Chloroquin den Säuregehalt in bestimmten Kompartimenten innerhalb der Zellen verringert: Hierdurch können Viren schlechter eindringen, eine Vermehrung findet nicht statt. Studien in Zellkulturen konnten zeigen, dass Chloroquine eine gewisse Aktivität gegen Sars-CoV-2 aufweist. Die erforderlichen Dosen für eine ausreichende Wirkung seien jedoch sehr hoch, sodass die Einnahme mit einer Vielzahl an Nebenwirkungen einhergeht und mitunter zu Vergiftungserscheinungen führen kann.
Die US-Regierung setzt große Hoffnungen in den über 60 Jahre alten Wirkstoff. Bei einer Pressekonferenz am Freitag bezeichnete Präsident Donald Trump Chloroquin und Hydroxychloroquin als „Game Changer“. "Ich fühle mich gut dabei", sagte Trump. Die Kombination solle „SOFORT“ eingesetzt werden, forderte er am Samstag über Twitter. „Was haben wir zu verlieren?“, fragte er im Anschluss bei einer Pressekonferenz im Weißen Haus. Der Direktor des Nationalen Instituts für Infektionskrankheiten, Anthony Fauci, bemühte sich im Weißen Haus dann auch, Trumps Begeisterung etwas zu relativieren: Es gebe bislang nur vereinzelte Berichte über eine Wirksamkeit des Medikaments, aber keine ernsthaften klinischen Studien. Fauci zufolge gehe es nun darum, das Medikament kontrolliert und begrenzt einzusetzen, um Daten über die Wirksamkeit zu gewinnen.
Das soll sich durch die Solidarity-Studie nun ändern. Es sollen neue Erkenntnisse darüber gewonnen werden, ob der Arzneistoff ausreichend wirksam gegen Covid-19 ist. Ursprünglich wollte das wissenschaftliche Gremium der WHO die beiden Wirkstoffe aus der Studie ausschließen, aufgrund des weltweit hohen Interesses hatte die WHO jedoch entschieden, die beiden Arzneistoffe in den Studienumfang mit aufzunehmen.
Immunsystemstärkung mit Tuberkulose-Impfung
Ein weiterer Ansatz zur Behandlung von Covid-19 befasst sich mit der Gabe von Tuberkulose Impfstoff. Forscher wollen nun in mindestens einer Phase-III-Studie untersuchen, ob der Impfstoffkandidat VPM1002, der ursprünglich von Wissenschaftlern des Max-Planck-Instituts für Infektionsbiologie gegen Tuberkulose entwickelt wurde, auch bei einer Corona-Infektion wirksam ist. Die großangelegte Studie soll an mehreren Kliniken in Deutschland durchgeführt werden. Als Teilnehmer werden nicht nur ältere Menschen, sondern auch das klinikeigene medizinische Personal herangezogen. Wissenschaftler hoffen, dass VPM1002 wirkt und die Zeit bis zur eigentlichen Impfstoff-Findung überbrücken kann. In Tierversuchen konnte gezeigt werden, dass der Impfstoff nicht nur vor Tuberkulose, sondern auch vor Virusinfektionen der Atemwege schützen kann.
Aussicht
Das Studiendesign ist zudem dynamisch. Wirkstoffe können ausscheiden und andere jederzeit hinzugefügt werden, wenn es einen begründeten Anhaltspunkt auf Wirksamkeit gibt. Ein globales Überwachungsgremium für Datensicherheit prüft in regelmäßigen Abständen die Zwischenergebnisse und entscheidet, ob ein Arzneistoff eine Wirkung hat oder nicht.
Aus den potentiellen Kandidaten der Solidarity-Studie geht hervor, dass „Remdesivir das beste Potenzial hat, in Kliniken eingesetzt zu werden“, so die Meinung des Wissenschaftlers Jiang Shibo von der Fudan-Universität in Shanghai, China, der seit langem an Coronavirus-Therapeutika arbeitet. Er sieht einen klaren Vorteil in dem Wirkstoff: Remdesivir scheint, auch bei der Gabe von hohen Dosen, relativ geringe Nebenwirkungen zu haben.

APOTHEKE ADHOC Debatte